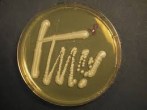
images (4)

මානව වර්ගයාගේ හිතවත්ම සත්වයා ලෙස සාමාන්යයෙන් සැලකෙන්නේ සුනඛයන්ය. එහෙත් ඒ ගැන වැඩි අවධානයකින් කල්පනා කර බැලූවොත් පෙනී යන්නේ මිනිසුන් වැඩි පිරිසකට සතුට අත්පත් කර දෙන්නට මග පාදන සත්වයා යිස්ට් බවයි. වඩාත් විශේෂිතව කීවොත් වයින් සෑදීමට, පාන් පිපීමට එමෙන්ම බියර් පැසීමට භාවිතා කරන යීස්ට් විශේෂය Saccharomyces cerevisiae තමයි. දැන් නව පර්යේෂණයන්ගෙන් පෙන්නුම් කරන්නේ මෙම පුදුම සහගත යීස්ට් විවිධ මාදිලිවලට, විවිධ කලාපීය කෝපි සහ චොකලට්වලට ඒවාෙය් සුවිශේෂී ස්වාදය (flavour = රසය) සැපයිය හැකි බවයි.

Saccharomyces cerevisiae යීස්ට් විශේෂය ආහාර පානවලට අමතරව වෙනත් ප්රයෝජන සඳහා ද යොදා ගැනේ. විද්යාඥයෝ සිය පර්යේෂණාගාරවලදී මෙම යීස්ට් බහුලව යොදා ගනිති. සිය පර්යේෂණයන් සඳහා ඊට හේතුවක් වන්නේ මෙම ඒක ෙසෙල ජිවීන් සතුව මානවයන්ගේ ෙසෙලවල ව්යුහයට සමාන ව්යුහයක් තිබීමයි. එමෙන්ම ඒවා බොහොමයක්ම ඉක්මනින් ප්රජනනය වේ (reproduce). ඖෂධ පරීක්ෂාකරීම පිණිස යීස්ට් යොදා ගැනීමටද යීස්ට්වල ජාන අධ්යයනයට ද මෙන්ම ඒවා අභ්යාවකාශයට යැවීමට පවා ද විද්යාඥයන් පෙළඹෙන්නේ එහෙයිනි.
 අයිමී ඩඞ්ලි ශාන්තිකර වයඹ දියවැඩියා පර්යේෂණ ආයතනයේ ප්රවේණි විද්යාඥවරියකි. Saccharomyces cerevisiae යීස්ට් විශේෂයේ විවිධ මාදිළිවල සිතියමක් සකස් කිරීමට ඇයට උවමනා විය. එහිදී ඇයට පෙනී ගියේ පර්යේෂන මගින් එක්රැස් කළ තොරතුරුවල අඩු පාඩු තිබෙන බවයි. දක්ෂණ අර්ධගෝලයේ මාදිලි රැසක්ම සොයා ගැනීමට නොහැකි බව හෙළි විණ. අපි්රකාව, ආසියාව දකුණු ඇමරිකාව සහ ඉන්දුනීසියාවෙන් වැඩිකොටසක් ඇතුළුව මේ ප්රදේශ සියල්ලට එම මාදිලි සෙවීම පිණිස යාම කාලය ගතවන්නකි. එමෙන්ම අධික වියදමක් වැයවන්නකි. ඩඞ්ලි ඇතුළු පර්යේෂක කණ්ඩායම ඒ අනුව තීරණය කළේ ඊළඟට කළ හැකි හොඳම දෙය කිරීමයි. කෝපි සහ චොකලට් පැසීමේ කි්රයාදාමයකට ලක්වන බව දන්නා හෙයින් පර්යේෂක පිරිස ලොව පුරා විවිධ ප්රදේශවලින් කෝපි හා කොකෝවා මිලට ගෙන යීස්ට් කෘෂ්ටි කිරීමකට(culture) ලක් කළහ.
අයිමී ඩඞ්ලි ශාන්තිකර වයඹ දියවැඩියා පර්යේෂණ ආයතනයේ ප්රවේණි විද්යාඥවරියකි. Saccharomyces cerevisiae යීස්ට් විශේෂයේ විවිධ මාදිළිවල සිතියමක් සකස් කිරීමට ඇයට උවමනා විය. එහිදී ඇයට පෙනී ගියේ පර්යේෂන මගින් එක්රැස් කළ තොරතුරුවල අඩු පාඩු තිබෙන බවයි. දක්ෂණ අර්ධගෝලයේ මාදිලි රැසක්ම සොයා ගැනීමට නොහැකි බව හෙළි විණ. අපි්රකාව, ආසියාව දකුණු ඇමරිකාව සහ ඉන්දුනීසියාවෙන් වැඩිකොටසක් ඇතුළුව මේ ප්රදේශ සියල්ලට එම මාදිලි සෙවීම පිණිස යාම කාලය ගතවන්නකි. එමෙන්ම අධික වියදමක් වැයවන්නකි. ඩඞ්ලි ඇතුළු පර්යේෂක කණ්ඩායම ඒ අනුව තීරණය කළේ ඊළඟට කළ හැකි හොඳම දෙය කිරීමයි. කෝපි සහ චොකලට් පැසීමේ කි්රයාදාමයකට ලක්වන බව දන්නා හෙයින් පර්යේෂක පිරිස ලොව පුරා විවිධ ප්රදේශවලින් කෝපි හා කොකෝවා මිලට ගෙන යීස්ට් කෘෂ්ටි කිරීමකට(culture) ලක් කළහ.
ඔවුන් අදහස් කළේ සියලූම සාම්පලවල එක සමාන මාදිලි සොයා ගැනීමට හැකිවෙතැයි යනුවෙනි. එහෙත් එය එසේ නොවීය. “අපට පෙනී ගිය අයුරු වඩාත්ම සිත් ඇදී ගිය කාරණය වුණේ ඒ (මාදිලි) සියල්ල එකිනෙකින් වෙනස් බව අපට පෙනී යාමයි “ඩඞ්ලි පවසයි. “ඉතින් කොළොම්බියාවේ කෝපි යීස්ට් මාදිලි අනෙක් කොලොම්බියානු මාදිලිවලට බොහෝ සමානයි. එහෙත් එම මාදිලිය යේමන කෝපි මාදිලියට වඩා ඇත්තටම වෙනස්”.
 පර්යේෂණයෙන් හෙළිවුණේ කෝපී සහ කොකෝවා යීස්ට් ඇත්තටම යීස්ට් මාදිලි තුනක එකතුවක් බවයි. ඒවා යුරෝපයට , ආසියාවට සහ උතුරු ඇමරිකාවට අයත් මාදිලිය. මානව සංක්රමණය තුළින් මෙකී මාදිලි ව්යප්තවන ආකාරය සහ එකතුවන ආකාරය පර්යේෂකයන් සඟරාවට සපයා ඇති පර්යේෂණ වාර්තාවෙහි දක්වා තිබේ. ප්රාදේශීය මාදිලි මානව සංක්රමණය මගින් එකට එකතුවීම සවිඤ්ඤානව මෙන්ම අවිඤ්ඤානව සිදුවේ.
පර්යේෂණයෙන් හෙළිවුණේ කෝපී සහ කොකෝවා යීස්ට් ඇත්තටම යීස්ට් මාදිලි තුනක එකතුවක් බවයි. ඒවා යුරෝපයට , ආසියාවට සහ උතුරු ඇමරිකාවට අයත් මාදිලිය. මානව සංක්රමණය තුළින් මෙකී මාදිලි ව්යප්තවන ආකාරය සහ එකතුවන ආකාරය පර්යේෂකයන් සඟරාවට සපයා ඇති පර්යේෂණ වාර්තාවෙහි දක්වා තිබේ. ප්රාදේශීය මාදිලි මානව සංක්රමණය මගින් එකට එකතුවීම සවිඤ්ඤානව මෙන්ම අවිඤ්ඤානව සිදුවේ.
“මානව ඉතිහාසය සහ යීස්ට් කොපමණ දුරට එකිනෙකට වෙළී ඇත්තදැයි තවදුරටත් පෙන්වා දෙන සාක්ෂි ලෙස මෙම පර්යේෂණ වාර්තාව දැක්විය හැකි “යයි ස්ටැන්ෆර්ඞ් සරසවියේ ප්රවේණි විද්යාඥවරියක වන බාර්බරා ඩන් පෙන්වා දෙයි.
වාර්තාව මගින් කොකෝවා හා කෝපි රසයට යීස්ට් බලපාන අන්දම ඍජුවම සොයා බලනු නොලැබුවත්, මේ ක්ෂුද්ර ජීවීන් විශාල බලපෑමක් ඇතිකිරීමට තිබෙන ඉඩකඩ අතිශය ඉහළය. “පැසවීම හා වියැලීම වෙනස් කිරීම තුලින් අපට එකම වර්ගයේ කෝපි ඇටවලින් එකිනෙකට වෙනස් රසයන් හයක් විශ්වාසදායක ලෙස ලබාගත හැකි ය ” යි පවසන්නේ චොකලට් විශේෂඥයෙකු වන ක්ලේ ගෝඩන්ය. එය සිදුකරන්නේ හුදෙක් පශ්චාත් අස්වනු කි්රයාදාමයන් තුළිනි. කාලගුණික තත්ත්වයන්, පස සහ ක්ෂුද්ර ජීවීන් කරනකොට ගෙන වයින්වල රසයෙහි සියුම් වෙනස්කම් ඇති කිරීම ගැන විද්යාඥයන් දැන හඳුනාගෙන ඇති දෙයට මේ වෙනස සමානය. ඕක්ලන්ඞ් විශ්වවිද්යාලයේ ප්රවේණි විද්යාඥ සාරා නයිට් පෙන්වා දෙන අන්දමට යීස්ට් ඒ ඒ වර්ගයෙන් සුවිශේෂී වූ පරිවෘත්තිජ(metabolites) මුදා හැරෙන අතර ඒවා වයින්වල ගතිලක්ෂණයට බලපායි. ඒ අනුව, ජානමය වශයෙන් වෙනස් වූ යීස්ට් ගහණයන් ඉතා සුළු වශයෙන් වෙනස් වූ සංයෝග එකට සාදමින් චොකලට්වල රසය හා ගන්ධය කෙරෙහි බලපෑමක් ඇති කිරීම ගැන පුදුම නොවන බව ද ඇය කියා සිටියි.
වාර්තාව මගින් කොකෝවා හා කෝපි රසයට යීස්ට් බලපාන අන්දම ඍජුවම සොයා බලනු නොලැබුවත්, මේ ක්ෂුද්ර ජීවීන් විශාල බලපෑමක් ඇතිකිරීමට තිබෙන ඉඩකඩ අතිශය ඉහළය. “පැසවීම හා වියැලීම වෙනස් කිරීම තුලින් අපට එකම වර්ගයේ කෝපි ඇටවලින් එකිනෙකට වෙනස් රසයන් හයක් විශ්වාසදායක ලෙස ලබාගත හැකි ය ” යි පවසන්නේ චොකලට් විශේෂඥයෙකු වන ක්ලේ ගෝඩන්ය. එය සිදුකරන්නේ හුදෙක් පශ්චාත් අස්වනු කි්රයාදාමයන් තුළිනි. කාලගුණික තත්ත්වයන්, පස සහ ක්ෂුද්ර ජීවීන් කරනකොට ගෙන වයින්වල රසයෙහි සියුම් වෙනස්කම් ඇති කිරීම ගැන විද්යාඥයන් දැන හඳුනාගෙන ඇති දෙයට මේ වෙනස සමානය. ඕක්ලන්ඞ් විශ්වවිද්යාලයේ ප්රවේණි විද්යාඥ සාරා නයිට් පෙන්වා දෙන අන්දමට යීස්ට් ඒ ඒ වර්ගයෙන් සුවිශේෂී වූ පරිවෘත්තිජ(metabolites) මුදා හැරෙන අතර ඒවා වයින්වල ගතිලක්ෂණයට බලපායි. ඒ අනුව, ජානමය වශයෙන් වෙනස් වූ යීස්ට් ගහණයන් ඉතා සුළු වශයෙන් වෙනස් වූ සංයෝග එකට සාදමින් චොකලට්වල රසය හා ගන්ධය කෙරෙහි බලපෑමක් ඇති කිරීම ගැන පුදුම නොවන බව ද ඇය කියා සිටියි.
Smithsonian.com හි 2016 මාර්තු 28 දා පළවූ Researchers find three unique strains of yeast that help ferment coffee and cacao beans and may give the treats their unique flavors ලිපිය ඇසුරෙනි





ප්රතිචාරයක් ලබාදෙන්න